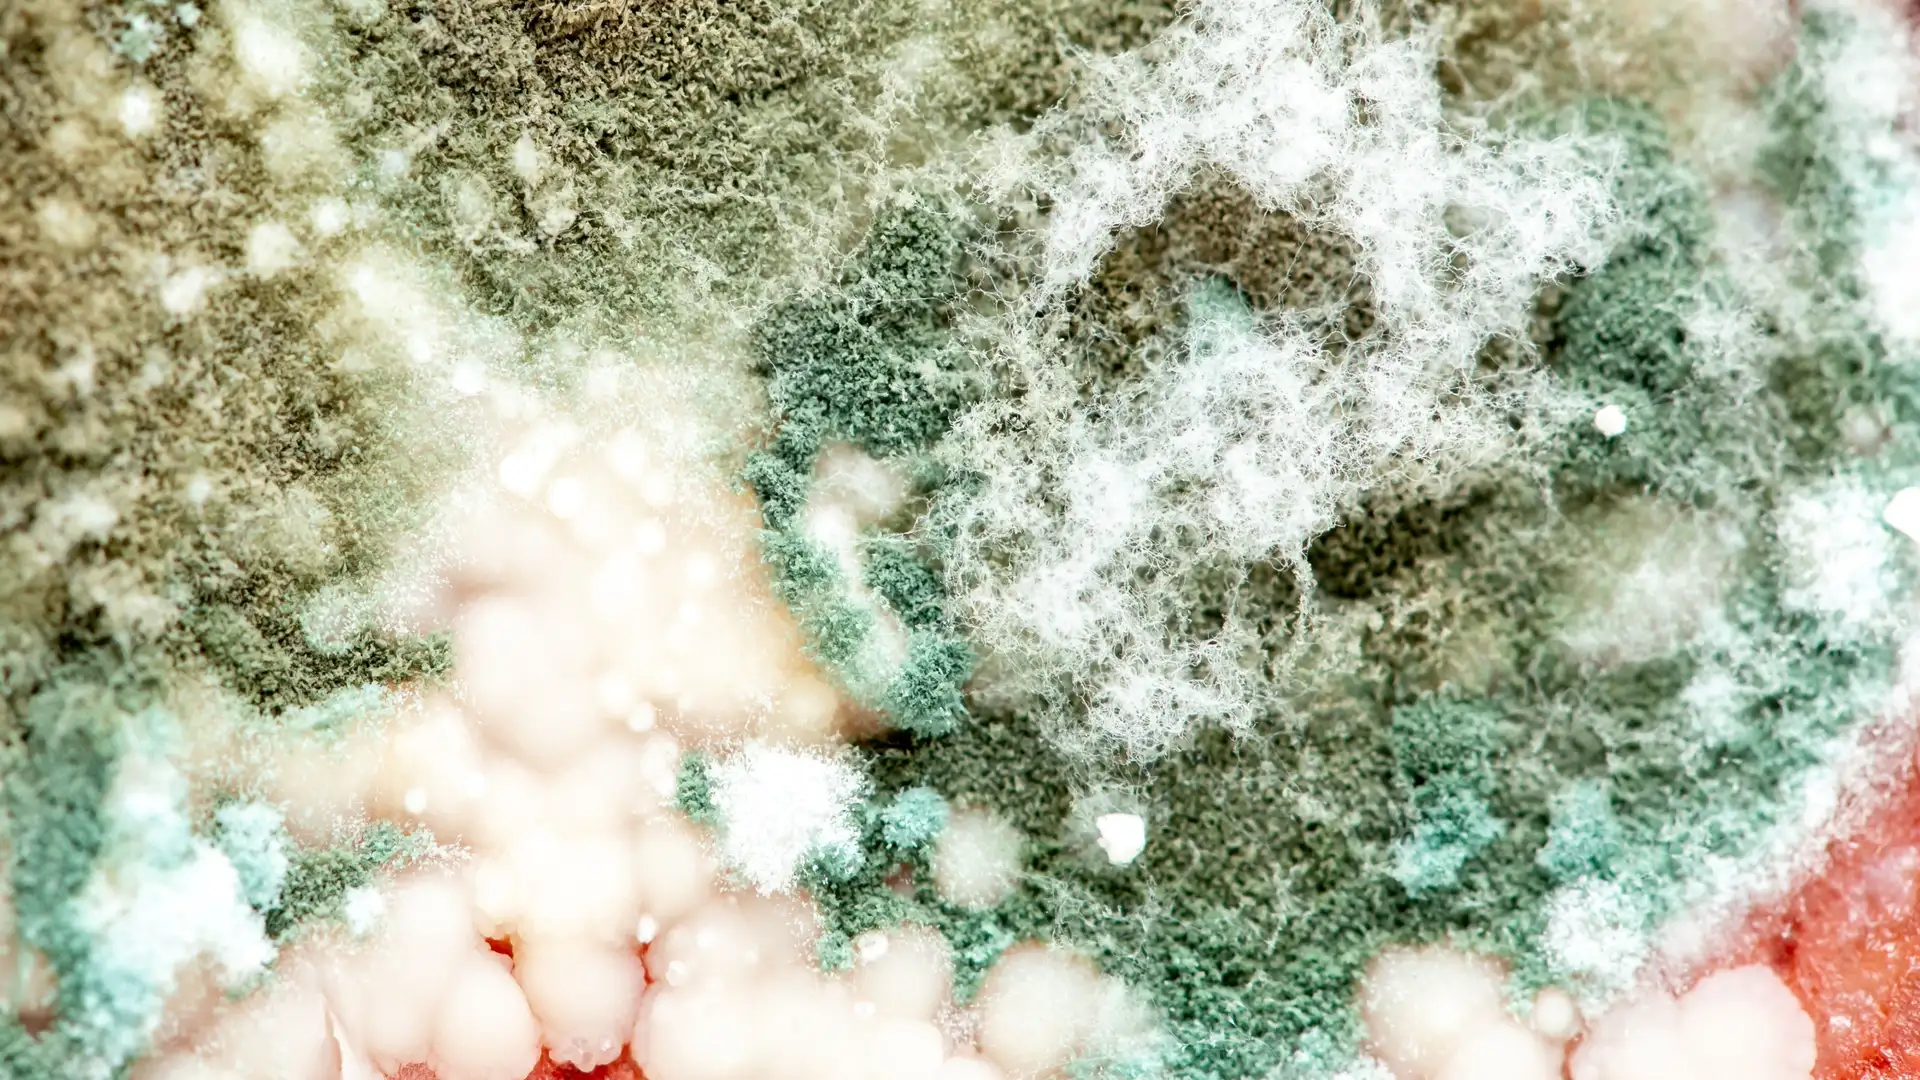
Koji

Koji Top of Mind with Julie Rose • Season 1, Episode 1806, Segment 2
Aug 14, 2022 • 19m
If you find mold on something in your kitchen, it goes straight in the trash, right? Well, there’s a certain kind of mold that you should be thrilled to find. It’s called koji and Chef Jeremy Umansky swears it makes almost anything taste better. Umansky owns Larder Delicatessen and Bakery in Cleveland, Ohio and is co-author of “Koji Alchemy: Rediscovering the Magic of Mold-Based Fermentation.” 
